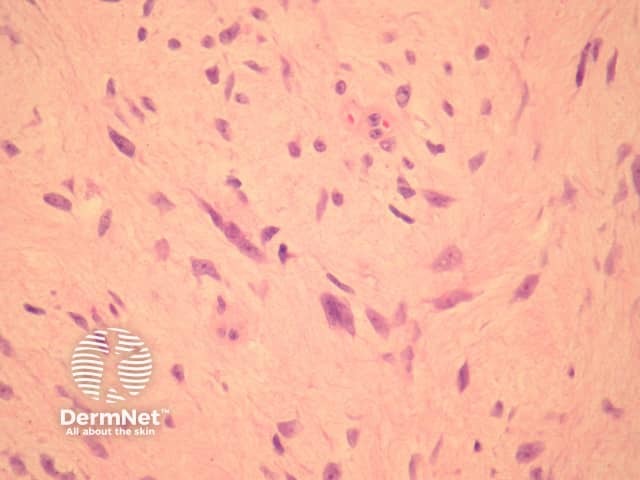
Figure 2

Main menu
Common skin conditions
NEWS
Join DermNet PRO
Read more
Quick links
Lesions (benign) Diagnosis and testing
Author: Assoc Prof Patrick Emanuel, Dermatopathologist, Auckland, New Zealand, 2013.
Giant cell fibroblastomas are skin and soft tissue tumours that usually arise in childhood. They are sometimes seen in association with dermatofibrosarcoma protuberans (DFSP, hybrid lesions) or may transform or recur as DFSP.
In giant cell fibroblastoma, the tumour is based in the dermis or subcutis. There are striking sinusoidal spaces mimicking blood vessels coursing through the tumour which is set in a myxoid, loose or sclerotic stroma (figure 1). Closer examination reveals the tumour is composed of epithelioid, stellate and spindled cells with occasional multinucleated forms (figures 2, 3). These cells often line the ecstatic vascular spaces. Mitoses are usually rare.

Figure 1
Figure 2

Figure 3
Immunohistochemical studies reveal the multinucleated cells are positive with CD34. The same gene abnormality seen in DFSP is seen in these tumours (PDGFB and COL1A1).
The sinusoidal spaces, giant cells and CD34 positivity typically allow easy distinction from other dermal tumours.
Dermal sarcoma: Marked nuclear polymorphism and frequent mitoses are seen.
Fibrosarcomatous dermatofibrosarcoma protuberans: This phenomenon is more cellular with increased nuclear pleomorphism and numerous mitotic figures. Staining for CD34 reduced.